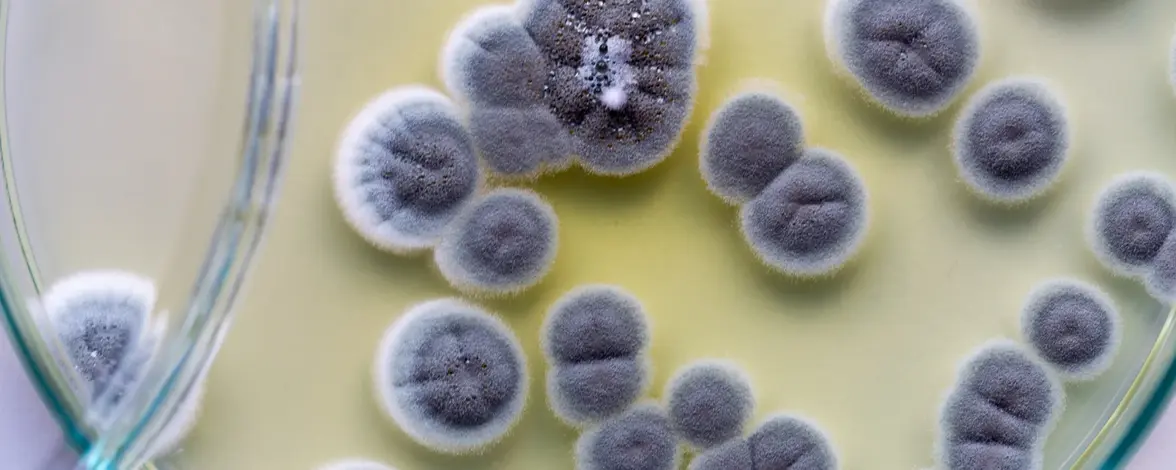
Как заплесневелая дыня помогла массовому производству пенициллина

Открытие в 1928 году плесени, обладающей антибактериальными свойствами, стало лишь первым счастливым случаем на долгом пути к пенициллину как спасительному лекарству.
В пыльном уголке лондонской больницы Святой Марии находится крошечный однокомнатный музей, посвященный одному из самых важных открытий в истории медицины - плесени, изменившей мир. Создатели музея воссоздали лабораторию Александра Флеминга в том виде, в каком она выглядела бы в день его открытия, - от сигарет, которые он постоянно курил, работая в лаборатории, до копии знаменитой чашки Петри с Penicillium.
Хотя образцы оригинального изолята, известного как Penicillium rubens IMI 15378, криоконсервированы в коллекциях по всему миру, этот штамм, как ни странно, не участвует в современном коммерческом производстве пенициллина. Изолят, используемый сегодня в массовом производстве, был получен вовсе не в лаборатории Флеминга; вместо него в многомиллиардной индустрии используется микроб, полученный из заплесневелой дыни, найденной на фруктовом рынке в Пеории, штат Иллинойс, в начале 1940-х годов.
В то время как случайность первоначального открытия Флеминга широко известна, последующие менее известные события не менее необычны: биограф Гвин Макфарлейн описал этот процесс как «серию случайных событий почти невероятной невероятности». Эти научные достижения окажут немедленное воздействие, предотвратив смерть от инфекции для несчетного числа солдат к концу Второй мировой войны, но также и долгосрочное влияние, последствия которого ощущаются и сегодня.
«Пенициллин - это, я бы сказал, самое важное лекарство, которое когда-либо появлялось»,
- говорит Роберт Гейнс, врач-инфекционист и историк медицины из Университета Эмори. «Оно полностью изменило наше представление об открытии лекарств», - продолжает он. «И оно во многом изменило фармацевтическую промышленность и представления о лечении инфекционных заболеваний».
Хотя открытие Флемингом необычных свойств Penicillium широко известно сегодня, в то время его публикация 1929 года не вызвала особого резонанса. По словам Гейнса, когда Флеминг представил свое исследование в Лондонском клубе медицинских исследований, ему не было задано ни одного вопроса. Флеминг наблюдал и тщательно отмечал воздействие плесени на бактерии, но ему, а также его все более разочаровывающемуся ассистенту не удавалось выделить само антибактериальное вещество. Тогда Флеминг обратился за помощью к Гарольду Рейстрику, биохимику из Лондонской школы тропической медицины и гигиены. Однако и группа Рейстрика через несколько лет отказалась от проекта, в основном из-за «советов друзей-медиков, что пенициллин никогда не сможет найти практического применения в клинической медицине из-за своей нестабильности».
Работа Флеминга могла бы быть отправлена на свалку истории, если бы Эрнст Чейн, в то время биохимик из Оксфордского университета, не нашел статью 1929 года почти десять лет спустя. Чейн и оксфордский патолог Говард Флори были мгновенно заинтригованы плесенью Флеминга, убивающей бактерии, и после этого их исследования быстро пошли в гору. К 1940 году оксфордская исследовательская группа, в которую также входил биохимик Норман Хитли, придумала, как вырастить плесень и очистить пенициллин, и показала, что он может спасти мышей от трех различных видов смертельных бактерий.
Испытания на людях начались почти сразу. 12 февраля 1941 года исследователи ввели первую дозу пенициллина человеку с опасной для жизни инфекцией Staphylococcus aureus. Уже через 24 часа его состояние значительно улучшилось, но к 17 февраля запасы пенициллина закончились. Инфекция вернулась и через месяц пациент умер. Исследователи понимали, что открытие и выделение этого почти чудодейственного вещества будет бессмысленным, если они не смогут придумать, как увеличить масштабы его производства. Но поскольку Вторая мировая война затянулась, а немецкие бомбы разрушили многие крупные города, у Британии не было ресурсов, чтобы выделить их на это масштабное предприятие. "Поэтому", - рассказывает Гейнс, - Флори был вынужден обратиться за помощью к Соединенным Штатам".
Весной 1941 года Флори встретился с Уорреном Уивером, директором Отдела естественных наук Фонда Рокфеллера, во время визита Уивера в Лондон. Флори объяснил свою неспособность произвести достаточное количество пенициллина в охваченной войной Великобритании. Уивер решил, что Фонд профинансирует поездку Флори и Хитли в США, где они смогут обратиться за помощью к государственным исследовательским институтам и фармацевтическим компаниям, чтобы воплотить свою мечту о массовом производстве пенициллина в реальность. Хотя США еще официально не вступили во Вторую мировую войну, правительство уже некоторое время оказывало помощь союзным державам и Флори решил, что американские ученые захотят присоединиться к их делу.
Итак, в июне того же года Флори и Хитли отправились в США, захватив с собой драгоценные культуры Penicillium. Первым делом они посетили Йельский университет, где работал профессором Джон Фултон, старый друг Флори. Через научные связи Фултона, а затем через цепочку других исследователей и правительственных чиновников Флори и Хитли добрались до Вашингтона, а затем до Северной региональной исследовательской лаборатории (NRRL) в Пеории, штат Иллинойс. Роберт Когхилл, руководитель Отдела ферментации NRRL, позже скажет: «Пенициллин часто называют чудо-препаратом, но одно из наиболее невероятных чудес, связанных с ним, заключается в том, что Флори и Хитли были направлены именно в нашу лабораторию в Пеории».
Их пребывание в Пеории было непродолжительным, но очень важным: дуэт поделился штаммом плесени Флеминга и всем, что они знали о ее культивировании. После того как пара оксфордских исследователей вернулась домой в начале 1942 года, ученые NRRL упорно работали над повышением выхода препарата. В Пеории произошло несколько важнейших событий, которые позволили пенициллину превратиться из крайне редкого вещества - настолько редкого, что на ранних этапах испытаний на людях пенициллин собирали и повторно использовали в моче пациентов - в клинически полезный продукт мирового значения.
Обладая многолетним опытом в области ферментации, группа NRRL разработала несколько методов увеличения роста интересующих микробов, которые они применили к штаммам Penicillium.
Во-первых, они использовали различные ингредиенты в культуральной среде, разработанной микологом NRRL Эндрю Мойером. Важным ингредиентом, по словам Гейнса, был «побочный продукт производства кукурузного крахмала, который назывался кукурузным сивушным маслом. Это был продукт переработки кукурузы, но на Среднем Западе с ним было очень плохо. И оказалось, что - опять же по счастливой случайности - он гораздо лучше подходит для выращивания пенициллиума, чем все, что использовал Хитли. Это был еще один пример невероятного везения».
Исследователи того времени считали так же. "[NRRL] была, я уверен, единственной лабораторией в стране, где была открыта эта кукурузная питательная среда", - утверждал Когхилл. » Выяснение ее ключевого места в пенициллиновой среде было предрешено и неизбежно, как только проблема была передана в наш отдел ферментации». Исследователи NRRL также повысили производительность, используя процесс погружной ферментации, при котором микробы выращивались в сосудах, подвергавшихся постоянному перемешиванию для их аэрации, вместо поверхностной ферментации, при которой микробы выращивались в больших плоских чашках.
Их полоса везения продолжалась. Когхилл вместе с Кеннетом Рэйпером и Дороти Александер, своими коллегами из Отдела ферментации NRRL, протестировали сотни штаммов Penicillium, чтобы определить, были ли среди них те, которые дают более высокий выход пенициллина, чем штамм Флеминга. Они собрали огромное количество образцов, выделяя микробы из заплесневелого хлеба, сыра, фруктов и овощей, а также прибегли к помощи Армейского транспортного корпуса, чтобы получить образцы почвы из разных стран мира, включая Англию, Бразилию, Австралию и Индию. Как отмечает Когхилл, "главная ирония этой всемирной охоты заключалась в том, что лучший из всех производителей был выращен из заплесневелой дыни, купленной на фруктовом рынке в Пеории".

Обычные лаборанты помогли разработать методы повышения производительности пенициллина. Женщина слева - это Мэри Хант, которая обнаружила штамм плесени с повышенной продуктивностью на фруктовом рынке в Пеории. Фото: United States Department of Agriculture.
Существуют некоторые разногласия по поводу того, кто именно нашел "дынный штамм" или Penicillium rubens NRRL 1951. В течение десятилетий после открытия местные газеты сообщали, что дыню нашла лаборант NRRL Мэри Хант по прозвищу «Плесневелая Мэри», и действительно, Хант указана в благодарностях к статье 1944 года, посвященной идентификации этого микроба. Когхилл, Рэпер и Александер написали: «Мы также обязаны мисс Мэри К. Хант за сбор образцов заплесневелых материалов и помощь в выделении и предварительном тестировании многих штаммов». Однако спустя годы Рэпер сказал одному журналисту, что дыню просто подбросила местная домохозяйка.
Независимо от того, кто его первоначально нашел, этот дынный штамм приобрел огромное значение в качестве «родителя», от которого были получены современные коммерческие штаммы. Значение этих разработок для ускорения массового производства пенициллина трудно переоценить: «В начале 1942 года у них вообще не было [пенициллина], но к концу 42-го у них было достаточно для первого клинического испытания», - говорит Гейнс. «А к концу 43-го у них было достаточно пенициллина для лечения всех вооруженных сил союзников... Это действительно было поразительное достижение». Однако работа исследователей из NRRL осталась практически непризнанной на мировой арене; Флеминг, Чейн и Флори, напротив, были удостоены Нобелевской премии по физиологии и медицине в 1945 году.
Следующие несколько десятилетий стали известны как «золотой век» открытия антибиотиков. Работа Селмана Ваксмана по изучению микробиологии почвы в Ратгерском университете привела к выделению стрептомицина, первого антибиотика, эффективного против Mycobacterium tuberculosis, в 1943 году. Девять лет спустя это открытие принесло ему Нобелевскую премию. В период с 1940 по 1970 год ученые открыли более 20 новых классов антибиотиков большинство из которых были получены из бактерий и грибков.
Однако вскоре темпы открытий резко замедлились. Несмотря на значительный технологический прогресс, в нынешнем столетии было создано сравнительно немного новых антибиотиков и противогрибковых препаратов. И хотя эти препараты в основном остаются неизменными, патогенные микробы - и вся планета - претерпевают быстрые и глубокие изменения. Темпы эволюции микроорганизмов не должны удивлять: в той самой работе 1941 года, в которой оксфордские исследователи опубликовали информацию о чудесных выздоровлениях пациентов, лечившихся пенициллином, они экспериментально продемонстрировали тревожно быстрое развитие устойчивости к антибиотикам. Они культивировали бактерии в постепенно увеличивающихся концентрациях пенициллина и уже через несколько месяцев отметили, что «микроб был способен размножаться в концентрации пенициллина, в тысячу раз превышающей ту, которая подавляла родительский штамм в параллельном тесте». Сегодня резистентные к антибиотикам бактерии убивают более миллиона человек в год; по оценкам исследователей, к 2050 году ежегодное количество смертей увеличится почти вдвое.
Как и в случае с пенициллином Флеминга, многие исследователи вновь обращаются к грибкам в поисках новых антибактериальных и противогрибковых средств. Среди них Нэнси Келлер, медицинский микробиолог из Университета Висконсин-Мэдисон и соучредитель компании Terra BioForge. Келлер и ее коллеги прочесывают геномы грибов в поисках групп генов, называемых кластерами биосинтетических генов (BGC), которые могут производить полезные вторичные метаболиты, включая те, которые могут выступать в качестве антимикробных препаратов.
Грибки тысячелетиями воюют с бактериями и другими видами грибков. По словам Келлер, «метаболиты, образующиеся из этих BGC, некоторые из них защищают от абиотических стрессов, таких как ультрафиолет... Большинство же из них можно рассматривать как оружие или броню для защиты от других микробов или для победы над ними».
Говоря о натуральных продуктах грибков, Келлер отметила, что большая часть "низко висящих фруктов" уже найдена, но она считает, что многие грибковые секреты еще предстоит открыть, если взглянуть на эти организмы свежим взглядом и с помощью новых технологий. «Если вы посмотрите на геном нитчатого грибка... можно предсказать, что грибки могут производить 50 или даже 70 метаболитов, а мы знаем лишь несколько из них для каждого грибка», - говорит Келлер. «Поэтому я считаю, что мы можем получить гораздо больше данных даже от окружающих нас грибков».
По мере того как стоимость секвенирования генома снижалась, публиковалось все больше и больше геномов грибков. Но отсортировать массу геномных данных, чтобы выявить BGC, которые могут производить новые метаболиты, - задача не из легких. Чтобы помочь в этом процессе, группа Келлер и другие исследовательские коллективы разрабатывают все более сложные биоинформатические алгоритмы.
По словам Келлер, один из способов выявления BGC - поиск генов, кодирующих различные типы базовых синтаз, которые создают «скелет», на котором строится остальная часть метаболита. Другие гены в кластере кодируют ферменты, которые добавляют элементы к основе для создания конечного продукта. Атласы BGC могут помочь исследователям определить, какие метаболиты не похожи на хорошо изученные природные продукты, что позволит им не тратить время на «открытие» одних и тех же продуктов снова и снова.
Работа различных исследовательских групп, включая группу Келлер, улучшила научное понимание того, как регулируется экспрессия BGC, что позволяет исследователям изменять геномы грибков для получения больших количеств интересующего метаболита. Если метаболит происходит из вида, который трудно культивировать или подвергнуть генетическим манипуляциям, исследователи могут использовать грибковые искусственные хромосомы - метод, разработанный Келлер в сотрудничестве с учеными Северо-Западного университета США и компанией Intact Genomics, - чтобы экспрессировать соответствующий кластер генов в более сговорчивом виде грибков. Список потенциальных натуральных продуктов продолжает расширяться: В 2023 году группа Келлер сообщила об алгоритме, позволяющем отбирать BGC с нетрадиционной основной синтазой, называемой изоцианид-синтазой, который выявил тысячи ранее неизвестных BGC, что указывает на огромное количество потенциально новых метаболитов.
Богатство новых технологий, а также огромное количество вторичных метаболитов, которые были обнаружены к настоящему времени, возродили интерес к открытию грибковых препаратов. В отличие от случайности и секретности, которыми характеризовалось открытие и разработка пенициллина, создание новых противомикробных средств, скорее всего, будет зависеть от методичных исследований и обмена геномными базами данных и биоинформатическими инструментами. Подобно событиям почти столетней давности, исследователи надеются, что грибки снова смогут защитить человечество от поражения смертельно опасными патогенами.
О создании пенициллина в нашей стране читайте в этой статье.